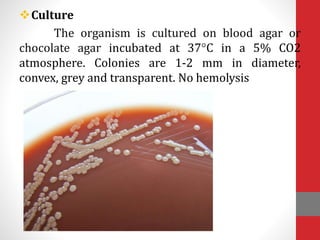
Culture
The organism is cultured on blood agar or
chocolate agar incubated at 37°C in a 5% CO2
atmosphere. Colonies are 1-2 mm in diameter,
convex, grey and transparent. No hemolysis
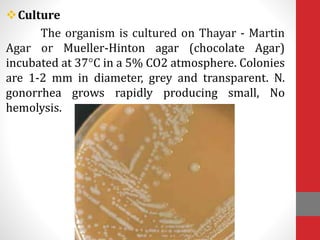
Culture
The organism is cultured on Thayar - Martin
Agar or Mueller-Hinton agar (chocolate Agar)
incubated at 37°C in a 5% CO2 atmosphere. Colonies
are 1-2 mm in diameter, grey and transparent. N.
gonorrhea grows rapidly producing small, No
hemolysis.

This document provides information on Neisseria meningitidis and Neisseria gonorrhoeae, including their morphology, culture characteristics, biochemical properties, virulence factors, pathogenesis, laboratory diagnosis, treatment and prevention. N. meningitidis can cause meningitis and meningococcemia, while N. gonorrhoeae causes gonorrhea, neonatal conjunctivitis and pelvic inflammatory disease. Both are Gram-negative diplococci that require special culture conditions and produce oxidase. Laboratory diagnosis involves Gram stain, culture, and tests for oxidase and sugar fermentation patterns. Treatment is generally with penicillin or related antibiotics.